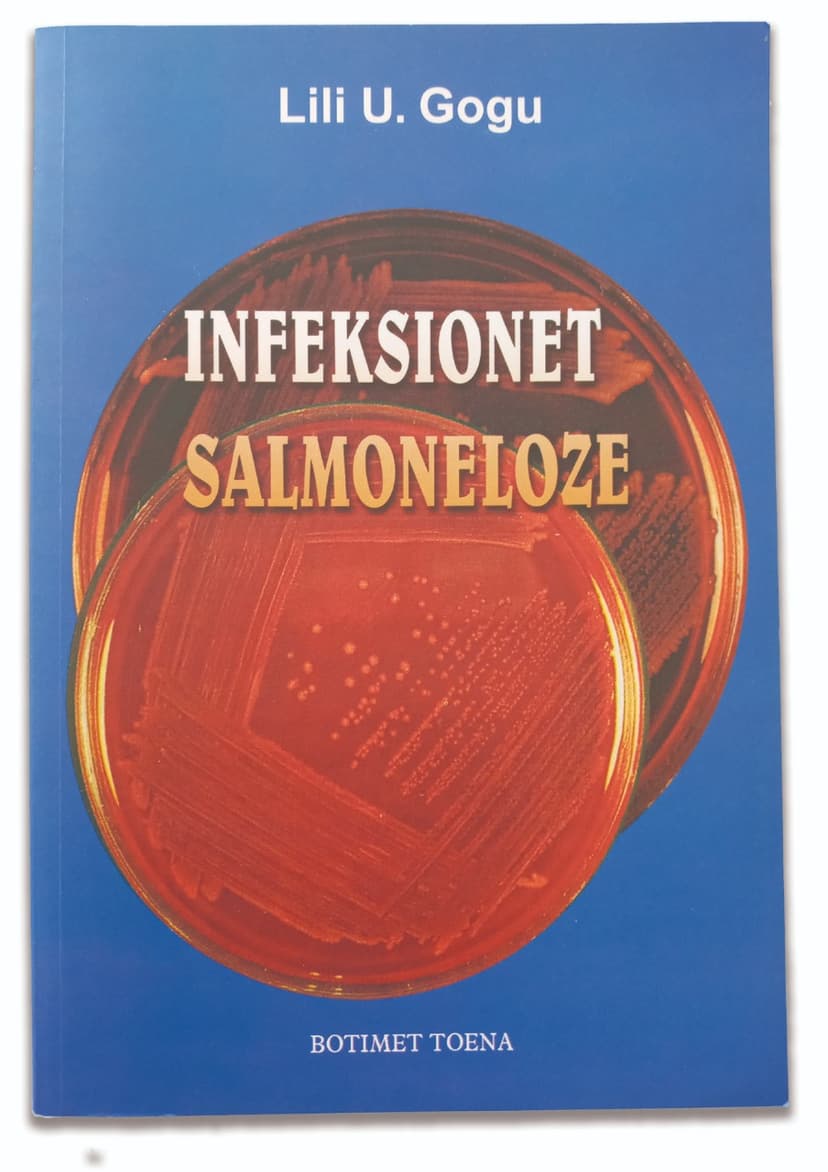
Infeksionet salmoneloze

Infeksionet salmoneloze
Ky libër do të thellojë më tej njohuritë e personelit mjekësor për njohjen në mënyrë shkencore të luftimit dhe prevenimit të sëmundjeve salmoneloze.
Detaje rreth librit
Zhaneri:
Shëndeti dhe Mirëqenia,
Shkencë dhe Natyra
Shtëpia botuese:
Toena
Numri i faqeve:
142
500 lekë
-
1
+
Infeksionet salmoneloze
Ky libër do të thellojë më tej njohuritë e personelit mjekësor për njohjen në mënyrë shkencore të luftimit dhe prevenimit të sëmundjeve salmoneloze.
Detaje rreth librit
Zhaneri:
Shëndeti dhe Mirëqenia,
Shkencë dhe Natyra
Shtëpia botuese:
Toena
Numri i faqeve:
142
500 lekë
-
1
+
Libra të tjerë nga e njëjta kategori











